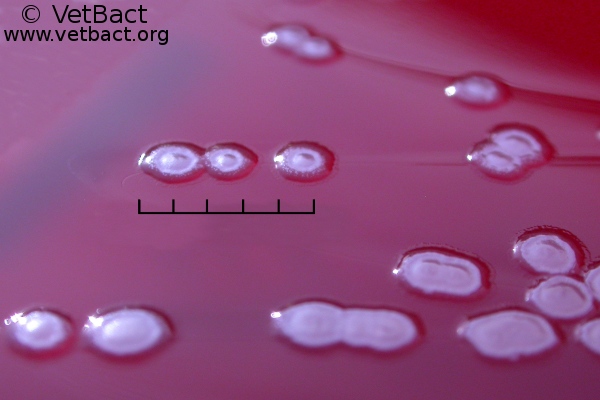
<i>Pseudomonas aeruginosa</i>

Pseudomonas aeruginosa
Fig. 65:3. Closeup of colonies of Pseudomonas aeruginosa, strain ATCC 27853, cultivated aerobically on horse blood agar during 3 days at 37°C. The total length of scale bar is equivalent to 5 mm. Date: 2010-10-06.
Credit: Karl-Erik Johansson (BVF, SLU & SVA) & Elisabeth Bagge (SVA).

This work is licensed under a Creative Commons Attribution 2.5 Sweden License.